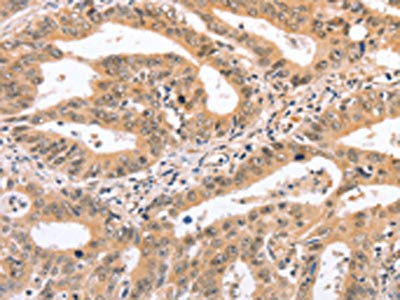

NCAM1 Antibody
-
中文名稱:NCAM1兔多克隆抗體
-
貨號(hào):CSB-PA087056
-
規(guī)格:¥1100
-
圖片:
-
The image on the left is immunohistochemistry of paraffin-embedded Human liver cancer tissue using CSB-PA087056(NCAM1 Antibody) at dilution 1/50, on the right is treated with synthetic peptide. (Original magnification: ×200)
-
The image on the left is immunohistochemistry of paraffin-embedded Human gastric cancer tissue using CSB-PA087056(NCAM1 Antibody) at dilution 1/50, on the right is treated with synthetic peptide. (Original magnification: ×200)
-
Gel: 6%SDS-PAGE, Lysate: 40 μg, Lane: 293T cells, Primary antibody: CSB-PA087056(NCAM1 Antibody) at dilution 1/400, Secondary antibody: Goat anti rabbit IgG at 1/8000 dilution, Exposure time: 40 seconds
-
-
其他:
產(chǎn)品詳情
-
Uniprot No.:
-
基因名:
-
別名:antigen MSK39 identified by monoclonal antibody 5.1H11 antibody; antigen recognized by monoclonal antibody 5.1H11 antibody; CD56 antibody; cell adhesion molecule, neural, 1 antibody; MSK 39 antibody; MSK39 antibody; N-CAM-1 antibody; NCAM 1 antibody; NCAM antibody; NCAM C antibody; NCAM-1 antibody; NCAM1 antibody; NCAM1_HUMAN antibody; NCAMC antibody; Neural cell adhesion molecule 1 antibody; Neural cell adhesion molecule NCAM antibody; OTTHUMP00000235666 antibody
-
宿主:Rabbit
-
反應(yīng)種屬:Human,Mouse,Rat
-
免疫原:Synthetic peptide of Human NCAM1
-
免疫原種屬:Homo sapiens (Human)
-
標(biāo)記方式:Non-conjugated
-
抗體亞型:IgG
-
純化方式:Antigen affinity purification
-
濃度:It differs from different batches. Please contact us to confirm it.
-
保存緩沖液:-20°C, pH7.4 PBS, 0.05% NaN3, 40% Glycerol
-
產(chǎn)品提供形式:Liquid
-
應(yīng)用范圍:ELISA,WB,IHC
-
推薦稀釋比:
Application Recommended Dilution ELISA 1:1000-1:5000 WB 1:500-1:2000 IHC 1:50-1:200 -
Protocols:
-
儲(chǔ)存條件:Upon receipt, store at -20°C or -80°C. Avoid repeated freeze.
-
貨期:Basically, we can dispatch the products out in 1-3 working days after receiving your orders. Delivery time maybe differs from different purchasing way or location, please kindly consult your local distributors for specific delivery time.
-
用途:For Research Use Only. Not for use in diagnostic or therapeutic procedures.
相關(guān)產(chǎn)品
靶點(diǎn)詳情
-
功能:This protein is a cell adhesion molecule involved in neuron-neuron adhesion, neurite fasciculation, outgrowth of neurites, etc.; (Microbial infection) Acts as a receptor for rabies virus.; (Microbial infection) Acts as a receptor for Zika virus.
-
基因功能參考文獻(xiàn):
- CD56 is a potentially good immunohistochemical marker for differentiating papillary thyroid carcinoma from other benign follicular lesions of the thyroid PMID: 30173227
- TROP-2, SLP-2 and CD56 were effective diagnostic markers for PTC, especially when they were combined to use. PMID: 29951933
- evaluation of the diagnostic value of emerin and CD56 in papillary thyroid carcinoma, using immunohistochemistry PMID: 30188764
- Plasma levels of NCAM-1 were found to be lower in coronary artery disease patients compared to controls. PMID: 29506702
- CD200(+) and/or CD56(+) positive expression in B-ALL patients at diagnosis is a poor prognostic biomarker. PMID: 29161980
- CD56 immunohistochemistry can be useful in differentiating follicular variant papillary thyroid carcinoma from follicular adenoma. PMID: 29799356
- NCAM1 protein expression levels were found to be regulated by miRNA-572 in an oligodendroglial cell line. PMID: 28332001
- a role for CD56 in developmental synapse structure, natural killer (NK) cell motility and NK cell development. PMID: 27435370
- The expression of CD56 was analyzed in 74 samples of primary MM cells collected from patients before they received bortezomib plus dexamethasone therapy. Expression of NCAM was lower among patients who responded poorly. In vitro expression of NCAM induced by transfection of MM cells enhanced their sensitivity to Btz treatment by causing accumulation of polyubiquitinated proteins. PMID: 29738534
- Results show that the conjugate selectively depleted the CSC population of the tumors and effectively inhibited tumor growth without causing toxicity. We propose that the NCAM-targeted conjugate could be an effective therapeutic for Wilms tumor. PMID: 28729402
- CD200 and/or CD56 positive expression in B-ALL at diagnosis suggest a poor prognosis and may be associated with biological aggressiveness. PMID: 29144828
- This study concludes that the cytotoxic action of CD56+ fraction of cytokine-induced killer cells against a K562 cell line is mainly due to the natural killer cells. PMID: 27136441
- NCAM1 was up-regulated in the malignant Middle Cerebral Artery Infarction. PMID: 28828208
- This supports the conclusion that a lower proportion of CD56(bright) natural killer regulatory cells results in the high rate of chronic graft-versus-host disease seen in filgrastim-stimulated apheresis peripheral blood. PMID: 28935847
- inhibiting NCAM1 would be cardioprotective, counteract the pathological action of TGFbeta1 and reduce heart failure severity. PMID: 28870505
- Mutation of a putative MAP kinase (Erk2) consensus site regulates neural cell adhesion molecule (NCAM) endocytosis and NCAM-dependent neurite outgrowth. PMID: 28193531
- The combined use of CK19 and CD56 is helpful in discriminating papillary thyroid carcinoma and its variants from other mimicking thyroid lesions. PMID: 28214214
- NCAM-expression in adult dilated cardiomyopathy hearts is associated with cardiomyocyte hypertrophy. PMID: 28343767
- This study identified NCAM1 gene sets related to self-reported depression scores in healthy participants PMID: 28334615
- Basal cell carcinoma (BCC) typically shows patchy CD56 expression and diffuse CK5/6 positivity. These 2 markers can be used to distinguish between BCC and Merkel cell carcinoma in challenging cases. PMID: 28403527
- Study represents the first to evaluate the prognostic impact of CD56 expression in a real-life setting and address these findings to a large and heterogeneous subset of AML. PMID: 26914377
- T-cell differentiation and CD56+ levels are different in polypoidal choroidal vasculopathy and neovascular age-related macular degeneration. PMID: 29165313
- findings that the CD56 and CD117 expression levels are lower in advanced stages than earlier stages and that LDH level and CD117 expression have an inverse relationship in patients with newly diagnosed multiple myeloma (MM) suggest that CD56 and CD117 expressions may be prognostic markers for MM. PMID: 28270374
- soluble NCAM might be thought as a specific marker of peripheral nerve demyelination and as a sensitive marker of peripheral nerve injuries PMID: 28336415
- Neural cell adhesion molecule (NCAM, CD56) is a transmembrane glycoprotein. PMID: 27528376
- Suggest that INSM1 is valuable for identification of the high-grade thoracic neuroendocrine carcinomas that are sometimes negative for synaptophysin, chromogranin, and CD56. PMID: 28719469
- CD56(bright) NK IL-7Ralpha expression negatively associates with HCV level, and IL-7-induced NK function is impaired during HCV and HIV infections PMID: 28400540
- These findings provide evidence for newly-discovered roles for PREP in mechanisms regulating cellular plasticity through NCAM and PSA-NCAM. PMID: 27566163
- NCAM- and FGF-2-mediated FGFR1 signaling in the tumor microenvironment regulates the survival and migration of esophageal squamous carcinoma cells. PMID: 27317650
- Study provides detailed description of the PSA-NCAM distribution throughout the human brain and quantitatively compares control, Alzheimer's and Parkinson's disease. Results demonstrate that PSA-NCAM-mediated structural plasticity may not be limited to neurogenic niches and is conserved in the aged brain, provide evidence that PSA-NCAM is reduced in the entorhinal cortex. PMID: 27282086
- The purpose of this study is to reveal whether neural cell adhesion molecule (NCAM) mediates the protective effects of GDNF. PMID: 27003822
- Suppressor function of CD56bright NK cells is impaired in multiple sclerosis. PMID: 27157273
- data provided molecular details about the interaction between HuPrP and the NCAM fibronectin domain, and revealed a new role of PrP(C) N terminus as a dynamic and functional element responsible for protein-protein interaction. PMID: 27535221
- The polybasic region of the polysialyltransferase ST8Sia-IV binds directly to NCAM. PMID: 28233978
- analysis of structural and genetic features of the CD56 glycoprotein, and summary of its roles in the normal versus diseased metanephric blastema [review] PMID: 27935326
- novel RUNX1 isoforms contribute in controlling CD56 expression in acute myeloid leukemia cells. PMID: 26706848
- NCAM1 SNPs were associated with lifetime cannabis use, but the association did not reach genome-wide significance. [Meta-Analysis] PMID: 27023175
- analysis of natural killer cell markers in renal transplantation that have roles in acute rejection reveals that CD56 and CD57 are increased in the interstitial compartment in donor-specific antibody (DSA)-negative biopsies from patients with acute antibody-mediated rejection without C4d, and CD16 is increased in the glomerular compartment in DSA-positive biopsies PMID: 26615051
- Data show that negative selection for CD133 is required for defining NCAM1(+) nephron stem cells in normal and malignant nephrogenesis. PMID: 27020553
- Report increased CD56 expression by immature biliary epithelial cells in biliary atresia. PMID: 26937142
- NCAM1 deletion is associated with neuroblastoma and ganglioneuroma. PMID: 26463893
- this study shows that CD56 expression defines a poor prognosis subset in the cytogenetically intermediate prognosis pediatric AML. PMID: 26147745
- The expression of coding and non-coding genes with SAFB1 cross-link sites was altered by SAFB1 knockdown. The isoform-specific expression of neural cell adhesion molecule (NCAM1) and ASTN2 was influenced by SAFB1. PMID: 26694817
- the expression of CD56 in adenomyosis is positively associated with the severity of dysmenorrhea. PMID: 26344352
- A FOXP3(+)CD3(+)CD56(+)-expressed T-cell population with immunosuppressive function and reduced patient survival has been identified in cancer tissues of human hepatocellular carcinoma. PMID: 26437631
- NK cell maturation to CD56(dim) subset associated with high levels of NCRs overrides the inhibitory effect of NKG2A and recovers impaired NK cell cytolytic potential after allogeneic hematopoietic stem cell transplantation. PMID: 26856773
- The neural cell adhesion molecule (NCAM) is a glycoprotein implicated in cell-cell adhesion, neurite outgrowth and synaptic plasticity. PMID: 26460482
- L1-CAM and N-CAM: From Adhesion Proteins to Pharmacological Targets PMID: 26478212
- CD56 marker is a useful alternative that is comparable to SSTR2A for the diagnosis of phosphaturic mesenchymal tumors. PMID: 26339384
- Case Report: chronic lymphocytic leukemia with aberrant CD56 and CD57 expression. PMID: 26013700
顯示更多
收起更多
-
亞細(xì)胞定位:[Isoform 1]: Cell membrane; Single-pass type I membrane protein.; [Isoform 2]: Cell membrane; Single-pass type I membrane protein.; [Isoform 3]: Cell membrane; Lipid-anchor, GPI-anchor.; [Isoform 4]: Cell membrane; Lipid-anchor, GPI-anchor.; [Isoform 5]: Secreted.; [Isoform 6]: Secreted.
-
數(shù)據(jù)庫(kù)鏈接:
Most popular with customers
-
-
YWHAB Recombinant Monoclonal Antibody
Applications: ELISA, WB, IHC, IF, FC
Species Reactivity: Human, Mouse, Rat
-
-
-
-
VDAC1 Recombinant Monoclonal Antibody
Applications: ELISA, WB, IHC
Species Reactivity: Human, Mouse, Rat
-
-